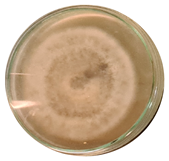
Microorganisms 11 00707 i001 Microorganisms 11 00707 i001
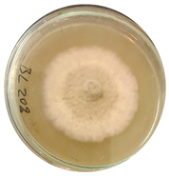
Microorganisms 11 00707 i003 Microorganisms 11 00707 i003
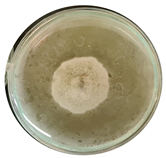
Microorganisms 11 00707 i005 Microorganisms 11 00707 i005
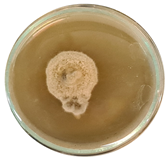
Microorganisms 11 00707 i006 Microorganisms 11 00707 i006
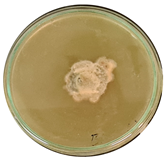
Microorganisms 11 00707 i007 Microorganisms 11 00707 i007
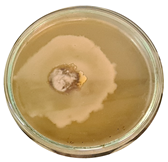
Microorganisms 11 00707 i008 Microorganisms 11 00707 i008
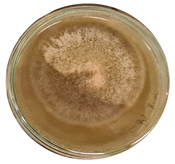
Microorganisms 11 00707 i010 Microorganisms 11 00707 i010
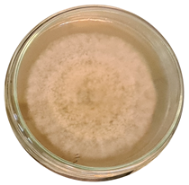
Microorganisms 11 00707 i013 Microorganisms 11 00707 i013

The Potential of Bacilli-Derived Biosurfactants as an Additive for Biocontrol against Alternaria alternata Plant Pathogenic Fungi
Abstract
1. Introduction
2. Materials and Methods
2.1. Bacteria
2.2. Pathogenic Fungi
2.3. Fermentation
2.4. Isolation of Biosurfactant
2.5. Antifungal Assay
- dc represents the diameter of the fungal colony in the control group (without biosurfactant), and
- dt represents the diameter of the fungal colony in the treatment group (with the biosurfactant).
2.6. Planting, Transplanting, Growing, and Treating Plants
2.7. Disease Incidence and Severity
2.8. Chlorophyll Concentration of Leaves
2.9. Data Analysis
3. Results
3.1. Fermentation
Verification of In-Line Sensor Usefulness
3.2. Antifungal Assay
3.3. Disease Incidence and Severity
3.4. Chlorophyll Concentration
3.5. Effect of Treatment and Infections on Plant Height
4. Discussion
5. Conclusions
Author Contributions
Funding
Data Availability Statement
Acknowledgments
Conflicts of Interest
References
- Markande, A.R.; Patel, D.; Varjani, S. A review on biosurfactants: Properties, applications and current developments. Bioresour. Technol. 2021, 330, 124963. [Google Scholar] [CrossRef]
- Bjerk, T.R.; Severino, P.; Jain, S.; Marques, C.; Silva, A.M.; Pashirova, T.; Souto, E.B. Biosurfactants: Properties and applications in drug delivery. Biotechnol. Ecotoxicol. Bioeng. 2021, 8, 115. [Google Scholar] [CrossRef]
- Joshi, S.J.; Al-Wahaibi, Y.M.; Al-Bahry, S.N.; Elshafie, A.E.; Al-Bemani, A.S.; Al-Bahri, A.; Al-Mandhari, M.S. Production, characterisation, and application of Bacillus licheniformis W16 Biosurfactant in enhancing oil recovery. Front. Microbiol. 2016, 7, 1853. [Google Scholar] [CrossRef]
- De Giani, A.; Zampolli, J.; Di Gennaro, P. Recent trends on biosurfactants with antimicrobial activity produced by bacteria associated with human health: Different perspectives on their properties, challenges, and potential applications. Front. Microbiol. 2021, 12, 655150. [Google Scholar] [CrossRef] [PubMed]
- Emmanuel ES, C.; Priya, S.S.; George, S. Isolation of biosurfactant from lactobacillus sp. and study of its inhibitory properties against e.coli biofilm. J. Pure Appl. Microbiol. 2019, 13, 403–411. [Google Scholar] [CrossRef]
- Hippolyte, M.T.; Augustin, M.; Hervé, T.M.; Robert, N.; Devappa, S. Application of response surface methodology to improve the production of antimicrobial biosurfactants by lactobacillus paracasei subsp. tolerans N2 using sugar cane molasses as substrate. Bioresour. Bioprocess. 2018, 5, 48. [Google Scholar] [CrossRef]
- Zhao, S.; Li, J.; Liu, J.; Xiao, S.; Yang, S.; Mei, J.; Ren, M.; Wu, S.; Zhang, H.; Yang, X. Secondary metabolites of Alternaria: A comprehensive review of chemical diversity and pharmacological properties. Front. Microbiol. 2023, 13. [Google Scholar] [CrossRef] [PubMed]
- Meena, M.; Samal, S. Alternaria host-specific (HSTs) toxins: An overview of chemical characterisation, target sites, regulation and their toxic effects. Toxicol. Rep. 2019, 6, 745–758. [Google Scholar] [CrossRef]
- Wang, J.-T.; Ma, Z.-H.; Wang, G.-K.; Xu, F.-Q.; Yu, Y.; Wang, G.; Peng, D.-Y.; Liu, J.-S. Chemical constituents from plant endophytic fungus Alternaria alternata. Nat. Prod. Res. 2019, 35, 1199–1206. [Google Scholar] [CrossRef]
- Chowdhary, A.; Agarwal, K.; Randhawa, H.S.; Kathuria, S.; Gaur, S.N.; Najafzadeh, M.J.; Roy, P.; Arora, N.; Khanna, G.; Meis, J.F. A rare case of allergic bronchopulmonary mycosis caused by Alternaria alternata. Med. Mycol. 2012, 50, 890–896. [Google Scholar] [CrossRef] [PubMed]
- Chandra, H.; Kumari, P.; Prasad, R.; Chandra Gupta, S.; Yadav, S. Antioxidant and antimicrobial activity displayed by a fungal endophyte Alternaria alternata isolated from Picrorhiza Kurroa from Garhwal Himalayas, India. Biocatal. Agric. Biotechnol. 2021, 33, 101955. [Google Scholar] [CrossRef]
- Singh, B.; Denning, D.W. Allergic bronchopulmonary mycosis due to Alternaria: Case report and review. Med. Mycol. Case Rep. 2012, 1, 20–23. [Google Scholar] [CrossRef]
- Kiss, B.; Németh, Á. Application of a high cell density capacitance sensor to different microorganisms. Period. Polytech. Chem. Eng. 2016, 60, 290–297. [Google Scholar] [CrossRef]
- Mitchell, D.A.; von Meien, O.F.; Krieger, N.; Dalsenter, F.D. A review of recent developments in modeling of microbial growth kinetics and intraparticle phenomena in solid-state fermentation. Biochem. Eng. J. 2004, 17, 15–26. [Google Scholar] [CrossRef]
- Kregiel, D.; Berlowska, J.; Szubzda, B. Novel permittivity test for determination of yeast surface charge and flocculation abilities. J. Ind. Microbiol. Biotechnol. 2012, 39, 1881–1886. [Google Scholar] [CrossRef]
- Gerzon, G.; Sheng, Y.; Kirkitadze, M. Process analytical technologies—Advances in Bioprocess Integration and future perspectives. J. Pharm. Biomed. Anal. 2022, 207, 114379. [Google Scholar] [CrossRef] [PubMed]
- Rathore, A.S. QBD/Pat for bioprocessing: Moving from theory to implementation. Curr. Opin. Chem. Eng. 2014, 6, 6. [Google Scholar] [CrossRef]
- Synkiewicz-Musialska, B.; Szwagierczak, D.; Kulawik, J.; Pałka, N.; Piasecki, P. Structural, thermal and dielectric properties of low dielectric permittivity cordierite-mullite-glass substrates at terahertz frequencies. Materials 2021, 14, 4030. [Google Scholar] [CrossRef]
- Mardanova, A.M.; Fanisovna Hadieva, G.; Tafkilevich Lutfullin, M.; Valer’evna Khilyas, I.; Farvazovna Minnullina, L.; Gadelevna Gilyazeva, A.; Mikhailovna Bogomolnaya, L.; Rashidovna Sharipova, M. Bacillus subtilis strains with antifungal activity against the phytopathogenic fungi. Agric. Sci. 2017, 8, 1–20. [Google Scholar] [CrossRef]
- Gomaa, E.Z. Antimicrobial activity of a biosurfactant produced by Bacillus licheniformis strain M104 grown on whey. Braz. Arch. Biol. Technol. 2013, 56, 259–268. [Google Scholar] [CrossRef]
- Kourmentza, K.; Gromada, X.; Michael, N.; Degraeve, C.; Vanier, G.; Ravallec, R.; Coutte, F.; Karatzas, K.A.; Jauregi, P. Antimicrobial activity of lipopeptide biosurfactants against foodborne pathogen and food spoilage microorganisms and their cytotoxicity. Front. Microbiol. 2021, 11, 561060. [Google Scholar] [CrossRef] [PubMed]
- Czinkóczky, R.; Sakiyo, J.; Eszterbauer, E.; Németh, Á. Prediction of surfactin fermentation with Bacillus subtilis DSM10 by response surface methodology optimised artificial neural network. Cell Biochem. Funct. 2023, 163, 107719. [Google Scholar] [CrossRef]
- Sakiyo, J.J.; Németh, Á. Optimisation of Bacillus licheniformis DSM13 for Biosurfactant production using response surface methodology. Hung. J. Ind. Chem. 2022, 50, 51–55. [Google Scholar] [CrossRef]
- Joshi, S.J.; Geetha, S.J.; Yadav, S.; Desai, A.J. Optimisation of bench-scale production of biosurfactant by Bacillus licheniformis R2. Apcbee Procedia 2013, 5, 232–236. [Google Scholar] [CrossRef]
- Joshi, S.; Bharucha, C.; Jha, S.; Yadav, S.; Nerurkar, A.; Desai, A.J. Biosurfactant production using molasses and whey under thermophilic conditions. Bioresour. Technol. 2008, 99, 195–199. [Google Scholar] [CrossRef]
- Czinkóczky, R.; Németh, Á. Techno-economic assessment of Bacillus fermentation to produce surfactin and lichenysin. Biochem. Eng. J. 2020, 163, 107719. [Google Scholar] [CrossRef]
- Kumar, S.N.; Nambisan, B.; Sundaresan, A.; Mohandas, C.; Anto, R.J. Isolation and identification of antimicrobial secondary metabolites from bacillus cereus associated with a rhabditid entomopathogenic nematode. Ann. Microbiol. 2013, 64, 209–218. [Google Scholar] [CrossRef]
- Gakuubi, M.M.; Maina, A.W.; Wagacha, J.M. Antifungal activity of essential oil of eucalyptus camaldulensis dehnh. against selected Fusarium spp. Int. J. Microbiol. 2017, 2017, 1–7. [Google Scholar] [CrossRef]
- Chiang, K.S.; Liu, H.I.; Bock, C.H. A discussion on disease severity index values. part I: Warning on inherent errors and suggestions to maximise accuracy. Ann. Appl. Biol. 2017, 171, 139–154. [Google Scholar] [CrossRef]
- Pérez-Patricio, M.; Camas-Anzueto, J.; Sanchez-Alegría, A.; Aguilar-González, A.; Gutiérrez-Miceli, F.; Escobar-Gómez, E.; Voisin, Y.; Rios-Rojas, C.; Grajales-Coutiño, R. Optical method for estimating the chlorophyll contents in plant leaves. Sensors 2018, 18, 650. [Google Scholar] [CrossRef]
- Czinkóczky, R.; Németh, A. Modeling the Biosurfactant Fermentation by Geobacillus stearothermophilus DSM2313. Period. Polytech. Chem. Eng. 2022, 67, 104–115. [Google Scholar] [CrossRef]
- DeMers, M. Alternaria alternata as endophyte and pathogen. Microbiology 2022, 168, 001153. [Google Scholar] [CrossRef] [PubMed]
- Delaye, L.; García-Guzmán, G.; Heil, M. Endophytes versus biotrophic and necrotrophic pathogens—Are fungal lifestyles evolutionarily stable traits? Fungal Div. 2013, 60, 125–135. [Google Scholar] [CrossRef]
- Rösner, L.; Walter, F.; Ude, C.; John, G.; Beutel, S. Sensors and techniques for on-line determination of cell viability in bioprocess monitoring. Bioengineering 2022, 9, 762. [Google Scholar] [CrossRef]
- Claßen, J.; Aupert, F.; Reardon, K.F.; Solle, D.; Scheper, T. Spectroscopic sensors for in-line bioprocess monitoring in research and Pharmaceutical Industrial Application. Anal. Bioanal. Chem. 2016, 409, 651–666. [Google Scholar] [CrossRef]
- El-Sheshtawy, H.S.; Aiad, I.; Osman, M.E.; Abo-ELnasr, A.A.; Kobisy, A.S. Production of biosurfactant from bacillus licheniformis for microbial enhanced oil recovery and inhibition the growth of sulfate reducing bacteria. Egypt. J. Pet. 2015, 24, 155–162. [Google Scholar] [CrossRef]
- Ali, N.; Wang, F.; Xu, B.; Safdar, B.; Ullah, A.; Naveed, M.; Wang, C.; Rashid, M.T. Production and application of biosurfactant produced by bacillus licheniformis ali5 in enhanced oil recovery and motor oil removal from contaminated sand. Molecules 2019, 24, 4448. [Google Scholar] [CrossRef]








| Pre-Treatment (Before Alternaria Infection) | Post-Treatment (After Alternaria Infection) | Non-Treatment | |
|---|---|---|---|
| B. licheniformis | BL-A | A-BL | BL-0 |
| B. subtilis | BS-A | A-BS | BS-0 |
| G. stearothermophilus | GS-A | A-GS | GS-0 |
| Extent of Infection | Score |
|---|---|
| infection | 0 |
| less than 1% of leaf infected | 1 |
| 1–10% of leaf infected | 2 |
| 11–25% of leaf infected | 3 |
| more than 25% of leaves infected, leaves still green | 4 |
| more than 25% of leaf-infected, leaf dead | 5 |
| 5% | 10% | 20% | 30% | |
|---|---|---|---|---|
| B. licheniformis | A![]() | B![]() | C![]() | D![]() |
| B. subtilis | E![]() | F![]() | G![]() | H![]() |
| G. stearothermophilus | I![]() | J![]() | K![]() | L![]() |
| Control | M![]() | |||
| Treatment | Concentration | Mean Average Growth of Mycelium (mm) | Inhibition of Mycelial Growth (%) |
|---|---|---|---|
| B. licheniformis | 5% | 65.45 ± 4.24 | 27.01 |
| 10% | 59.89 ± 9.90 | 33.22 | |
| 20% | 55.38 ± 7.07 | 38.24 | |
| 30% | 23.23 ± 5.66 | 74.09 | |
| B. subtilis | 5% | 32.84 ± 2.51 | 63.38 |
| 10% | 29.13 ± 4.95 | 67.51 | |
| 20% | 23.22 ± 4.72 | 74.10 | |
| 30% | 19.92 ± 9.19 | 77.78 | |
| G. stearothermophilus | 5% | 67.74 ± 8.03 | 24.46 |
| 10% | 63.81 ± 8.08 | 28.84 | |
| 20% | 47.68 ± 5.95 | 46.83 | |
| 30% | 18 ± 8.99 | 79.93 | |
| Control | 89.67 ± 2.19 | 0.00 |
Disclaimer/Publisher’s Note: The statements, opinions and data contained in all publications are solely those of the individual author(s) and contributor(s) and not of MDPI and/or the editor(s). MDPI and/or the editor(s) disclaim responsibility for any injury to people or property resulting from any ideas, methods, instructions or products referred to in the content. |
© 2023 by the authors. Licensee MDPI, Basel, Switzerland. This article is an open access article distributed under the terms and conditions of the Creative Commons Attribution (CC BY) license (https://creativecommons.org/licenses/by/4.0/).
Share and Cite
Sakiyo, J.J.; Németh, Á. The Potential of Bacilli-Derived Biosurfactants as an Additive for Biocontrol against Alternaria alternata Plant Pathogenic Fungi. Microorganisms 2023, 11, 707. https://doi.org/10.3390/microorganisms11030707
Sakiyo JJ, Németh Á. The Potential of Bacilli-Derived Biosurfactants as an Additive for Biocontrol against Alternaria alternata Plant Pathogenic Fungi. Microorganisms. 2023; 11(3):707. https://doi.org/10.3390/microorganisms11030707
Chicago/Turabian StyleSakiyo, Jesse John, and Áron Németh. 2023. "The Potential of Bacilli-Derived Biosurfactants as an Additive for Biocontrol against Alternaria alternata Plant Pathogenic Fungi" Microorganisms 11, no. 3: 707. https://doi.org/10.3390/microorganisms11030707
APA StyleSakiyo, J. J., & Németh, Á. (2023). The Potential of Bacilli-Derived Biosurfactants as an Additive for Biocontrol against Alternaria alternata Plant Pathogenic Fungi. Microorganisms, 11(3), 707. https://doi.org/10.3390/microorganisms11030707